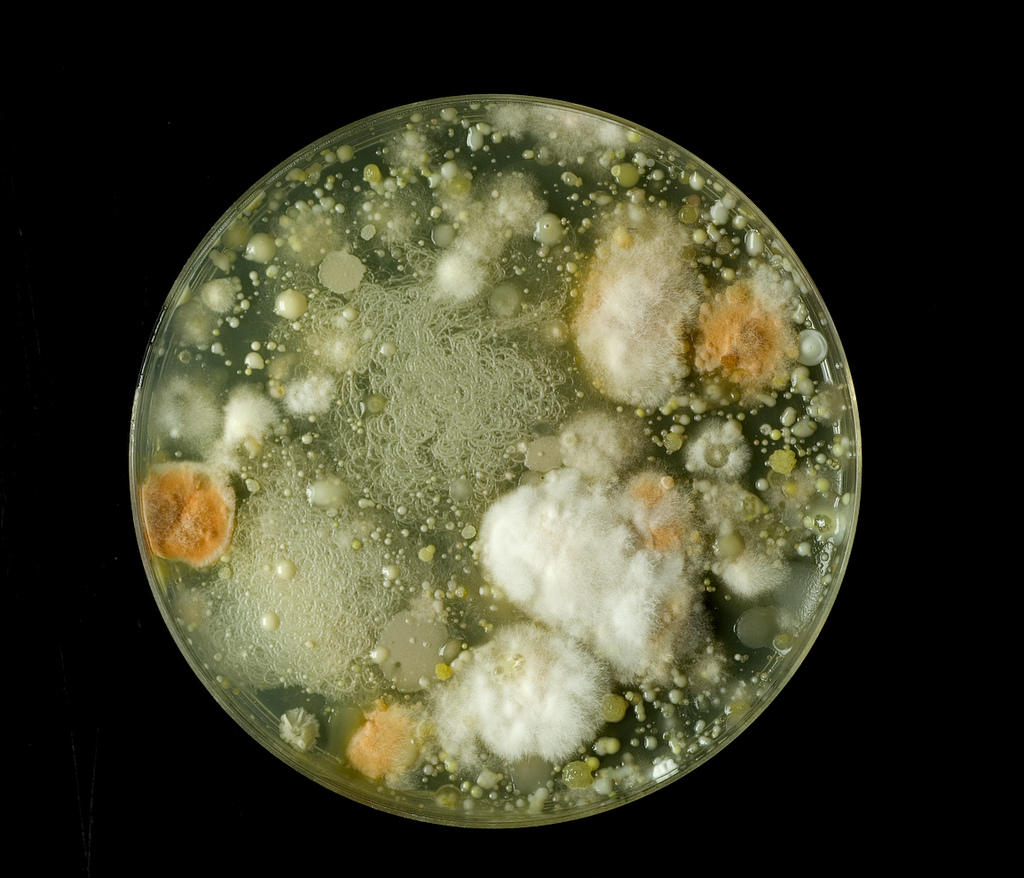

If you are a budding scientist, you may want to invest in a chemistry lab at home – a place where you can experiment with chemical reactions to your heart's content. Maybe a whole laboratory in your household is a little ambitious, but there are science kits available – for kids and for adults – which can turn anybody into an amateur chemist!
Before you go and buy anything, have a look at this list of the essential lab equipment you will need to turn your kitchen into a place to cook up science experiments!
Moving on, here is a review of the history of chemistry sets:
History Of Chemistry Sets
The era between the 1920s and 1960s is when it became necessary for all students to have chemistry equipment.
It was a time all manufacturers proudly boasted that you could find a chemistry set in every street and household of America. But, unfortunately, most of them consisted of outrageously hazardous chemicals.
These sets were designed for advanced chemistry purposes and could be dangerous. However, they no longer exist, and now chemistry sets are made to prepare kids for a career in science.
The time of the Great Depression and those difficult interwar years compelled a different way of thinking. There was now a spotlight on scientists and inventors, and parents signed their children up!
As a result, the idea that working with chemicals can result in a well-paid and stable career appealed to many parents in those war-stricken days.
However, preparing their kids for a career in science most often meant exposing them to all sorts of chemicals and processes.
And most of these processes' were only meant to be used by scientists under a controlled environment and with personal protection equipment.
Hence, some of the dangerous items that graced children's chemistry sets in those days included:
- Hot plates
- Blowtorches
- Cyanide
- Glass blowing equipment
- Uranium (highly radioactive)
Moreover, one of those sets even had copper sulfate packed inside a container featuring crossbones and skull with the words 'Caution: Poison.'
The Predictable Decline Of Old Chemistry Sets
When you look at the types of chemistry equipment children were encouraged to work with, it comes as no surprise that those sets have been phased out of usage. No parent wants their child to play with poison.
And this decline was not only due to safety and health factors; there were several other reasons:
For example, some sets came with iodine solutions, known for testing starch in food or a solution. However, it can also be used to help create methamphetamine.
Chemistry is a discipline that can be used for good and evil. Hence, you want your child to take inspiration from Pasteur and Noble and not Heisenberg!
All those bangs, flashes, and dodgy experiments of the '70s were gone and replaced with simple experiments involving the use of household chemicals like table salt, vinegar, and baking soda.
The chemistry sets of the late 20th century might no doubt have been safer; however, they were so dull and uninspiring that some even believe that they robbed us of a few generations of scientists.
The decline in the quality of chemistry sets ultimately resulted in fewer young adults going for a scientific career. Instead, children were pushed to pursue safer careers such as finance and law.
Check for qualified chemistry tutor here.
The Basic Chemistry Equipment: Test Tubes And Other Containers

Test Tubes
Firstly, you can't do anything at all to do with chemistry without test tubes. Not only are they the iconic tool of chemistry experiment, but they are specially designed and shaped to make your dealings with chemical reactions easier. They won't break if you heat them or corrode if you fill them with acids or dangerous elements, and they are super easy to clean, store, and look into (that's why scientists use them!).
If you want some test tubes, however, you will probably need a test tube rack – so that your substances and solutions don't flow all over your table! You may also want to think about boiling tubes, which are a bigger variety of test tube ideal for heating up liquids.
Learn about different organic chemistry tutor in Boston here.

Flasks
Chemistry is full of flasks, different bits of glassware in which to dissolve and observe your solutions. Whilst they are not all necessary for your chemistry kits – because there are potentially hundreds of different specialty items – there are few from which your set might benefit.
The beaker is used for measuring liquids, as it comes with measurements on the side and a spout (or a 'beak'!) for pouring.
The conical flask – or the Erlenmeyer flask – is recognizable by its inward-sloping sides. Its shape is designed with two things in mind. You can swirl the solution without having to stir it and without risking spillage. The shape of the flask makes it ideal for boiling liquids, as the wide base and the tapered sides allow the condensation of vapors along the side!
Burette
A burette is a fancy name for a test tube with a tap at one end. It is graduated, too – meaning that the liquid measurements are written on the side. These two things allow for the very precise release of solutions – something you will need if you are hoping to take your chemistry experiments to the next level!
Pipette
Imagine a teeny tiny plastic test tube which, when you squeeze it, it takes in liquid. It is primarily used for transferring liquids from one test tube to the next.
Petri Dish
More classically known for its use in biology – for growing and studying bacteria – petri dishes are also used by chemists to hold crystals. The glass ones are a bit better than the plastic ones, but both can be used by a home chemist!
Any idea what was discovered in a petri dish? Find out in our piece on chemistry discoveries!
Safety Equipment for Your Chemistry Experiments
Goggles and Gloves
Whilst you might have all your fun things ready to go, you shouldn't really be starting anything with chemicals, acids, or bases without the proper safety equipment. Goggles for eye protection and chemical-resistant gloves for your hands are absolutely essential.
Some of the things with which you might be working can be dangerous. Even if not, it's not nice to get them on your hands – and it's always fun to pretend to be a mad scientist!
Boss and Clamp
If you are fiddling around with your experiments, how do you expect to have enough hands to hold everything? This is precisely what the boss and clamp are for. The boss is a weighted standing shaft, to which you can clamp anything you don't always need to hold.
Think about a burette. If you are dripping solution into another solution, you can attach it to the boss, and all good! It is safer, easier, and every proper scientist uses one.
The Necessary Extras: The Things you Need to Understand Chemistry
Thermometer
So, what's going on with that experiment of yours? Is it hot or cold? At what temperature does a certain chemical react with another, and at what temperature does it change state, from solid to liquid to gas? How are you going to know anything about the temperature of your experiment without a thermometer?
This little piece of kit is really important if you are going to do anything of any interest with your chemistry equipment at home, and it is a must-have if you are seeking to understand anything too! Chemicals behave very differently at different temperatures – so make sure you get it right!
What about chemistry tutors? They're there to make sure you get it right!
Search for different organic chemistry tutor in Dallas here.

Litmus Paper
In that test tube of yours, you have a solution. But what is it, and how are you supposed to find out?
If you have any interest in knowing about acids and bases – a fairly fundamental part of chemistry! – You will need to have some litmus paper. This usually comes in strips of either red or blue, and they show you how acidic or alkali your solution is. If the blue bit turns red, you have an acid; if the red turns blue, you have an alkali; if the whole thing goes purple, it's neutral!
There's a couple of rad facts about acids and alkalis, which we're ready to bet you didn't know, in our piece on cool facts about chemistry!

The Periodic Table
Every classroom laboratory has one. And you're not going to understand anything that is going on in your chemistry experiments without one. This is the periodic table, the table of the elements, the chart that tells you exactly what each element is, what it is like, and what it can react with – as long as you know how to read it!
The periodic table is arranged by atomic number – or the number of protons in the nucleus of each atom – and by the reactivity of each element. This table will show you precisely why fluorine and cesium are so reactive and will help you understand what happens when two different elements react.
Chemistry glossary - need to know here.
Molecular Models
Whilst the periodic table can show you in numerical terms what is going on in a given atom; molecular models offer a practical way to understand how molecules and compounds are formed. For an explanation of precisely this, see our pieces on basic chemistry concepts or the essential chemistry terminology!
If you buy them, they are usually made of plastic and come with balls (representing atoms) and sticks (representing chemical bonds). The joy of these models is that you can build any molecule you want and actually see what is going on at a chemical level in your test tube.
You can even make your own. Just get some little different colored balls and some string or straws – and make all the molecules you could possibly want!
Getting Serious: The Pro Kit for Kitchen Chemistry
Bunsen burner
Honestly, this probably isn't going to be something you will need at home – although we all can dream!
The Bunsen burner is a tool that produces a very clean and clear flame from gas, and it is super useful in heating up solutions, burning elements for oxidization, and seeing how substances react to heat.
However, the problem is that they need to be connected to the gas mains – and if you are a kid, your parents might not really trust you to use that (although, if you are an adult, your neighbors might not trust you either)! They can be a little tricky to have installed at home.
If you are serious, however, and if you are a very ambitious scientist, then go for it! No science experiment is complete without a Bunsen!
Any idea why it's called a Bunsen burner? Check out piece on the world's incredible chemists to find out.
Tripod and gauze
If you are using a Bunsen, you've got to remember one fairly obvious thing: stuff gets really hot when you put it over a flame!
This is what a tripod and gauze are for: the tripod sits neatly over the Bunsen burner, and things – such as a conical flask – can be placed upon it in order to be heated up without you touching them; the gauze sits beneath the flask and spreads out the heat, so the whole thing warms up evenly!
Anything more you want to know about chemistry? We're sure you'll find it in our guide to everything you need to study chemistry!
Now that we've discussed what you would need for an introductory chemistry set, keep reading as we outline some other things that you must consider before starting.
Whether you're a student or teacher, these measures will surely help you:
Safety Precautions In A Chemistry Lab
Lab safety is a critical concern when working around hazardous chemicals, heavy-duty equipment, and medical supplies.
Since there is a high probability of accidents while working in a lab, paying attention to care and usage of volatile equipment is crucial.
Laboratory work is a high-risk environment; therefore, lab experts and technicians are trained to be well informed of preventive measures.
Hence, before entering a lab, there are certain safety checks to be made. These include wearing personal protective gear to adequately handling toxic chemicals.
Here are certain rules that you must follow while working in a chemistry lab;
Wear Personal Protective Equipment
While working in a chemistry lab, you have to wear the proper protective gear to stay safe. Safety goggles, lab coats, and closed-toe shoes must become a part of your daily uniform when working with tissue samples or toxic chemicals.
Moreover, you would also have to tie your hair back and away from your face to avoid contaminating any testing material.
Getting your hair out of the way is also essential when working with various flammable chemicals and materials.
Handling Chemicals With Care
Whenever you are tasked with handling fragile or volatile equipment, be sure to read the directives on the label to learn how to do it properly.
The proper way to handle most equipment is to wear gloves, protecting yourself from exposure or spillage.
Another thing to keep in mind is that you should never put chemicals back into the container they came from. This is because it will contaminate the solution that hasn't yet been exposed to the atmosphere.
Suitable Care Of Equipment
A chemistry lab is fitted with several heavy-duty pieces of equipment necessary to test the samples being brought in. And each apparatus must be operated with extra caution and care.
Hence, you should train yourself properly on equipment usage and never shy away from asking questions when confused.
For instance, to handle hot glassware, always use tongs and never carry testing samples with one hand – always use two!
Locate The Emergency Exit And Equipment
All chemistry labs must also have preventive and protective tools to fight exposure to flames or toxic chemicals. This list usually includes overhead sprinklers, eye rinse, or fire extinguishers.
You must also train yourself with emergency equipment to learn the standard operating procedures in case of outbreaks or emergencies.
A Lab Is Not A Cafeteria
Always keep drinks and food out of your chemistry lab. The edibles you bring into the lab can taint testing samples, or worse, it could work the other way. You don't want to get poisoned!
And if your food does diminish the integrity of the samples, it would produce inaccurate results that require retesting.
With drinks, you also risk spilling, which will create a mess and tripping hazard in the chemistry lab. Furthermore, if you spill on expensive equipment, that will set the lab back in time and money.
Final Checks
Safety in a lab environment has to be a number one priority, especially when entertaining new students. Unfortunately, the chances of accidents increase with those that are new to a lab. They may playfully mishandle chemicals, resulting in lethal or fatal accidents.
Ensure that all the students in the lab wear their safety gear, including:
- Googles
- Lab coats
- Aprons
- Gloves
Another step taken by many chemistry lab teachers is substituting certain substances or objects with user-friendly versions to reduce the chances of accidents.
For example, to avoid possible mercury spills, many chemistry lab teachers use digital thermometers instead.
Similarly, another chemical that is widely substituted is lead chromate which is replaced by copper carbonate.
Moreover, some volatile chemicals are overlooked for materials like dish soap which can emulate the properties of a specific chemical.
As a result of all of these things, student training is essential; it stresses the basics of lab safety before newcomers can enter the lab.
This is because most of them are not familiar with handling chemicals properly, cleaning test tubes, lighting Bunsen burners, etc.
Hence, signage is a great way to eliminate any confusion for students. Additionally, you can also use slip-proof mats on the floor to further prevent accidents.
Check out organic chemistry tutor here on Superprof.
Chemicals Required In A Chemistry Lab
As a new chemistry teacher, you may want to know what chemicals are suitable to stock in a school lab. Firstly, this list will depend on your yearly curriculum. Ask yourself:
- What are you teaching?
- What experiments will you be doing over the year?
- What grade levels are you teaching?
Moreover, it is also integral to choose laboratory-grade chemicals or higher when placing an order for a school lab.
Without further ado, here is a comprehensive list of high school chemistry lab chemicals to choose from:
- Ammonium Hydroxide
- Acetic Acid
- Acetone
- Copper Sulfate – Pentahydrate
- Calcium Carbonate
- Corn Starch – Powdered
- Calcium Chloride – Granular
- Dextrose – Powdered
- Ethanol 200 Proof
- HCl (Hydrochloric Acid)
- Iodine and Potassium Iodide Solution
- Ferric Chloride Solution
- Isopropyl Alcohol – (70% or 99%)
- Methanol
- Magnesium – Ribbons
- Potassium Hydroxide
- Phenolphthalein
- Potassium Iodide
- Potassium Chloride
- Sodium Bicarbonate
- Sodium Acetate
- Sodium Carbonate – Anhydrous
- Sodium Borate
- Sodium Hydroxide
- Sodium Chloride
- Sulfuric Acid
- Distilled Water – HPLC Grade
- Zinc

Best Storage Practices For A High-School Chemistry Lab
Once you have gathered your inventory, you should now focus on storing them. This is arguably the most critical part because if not stored properly, the school would be held responsible in the event of an accident.
- Pay maximum attention to chemical compatibility; do not store chemicals together if they react well. For instance, do not place volatile compounds like ethanol or isopropyl alcohol near anything they can react with
- Likewise, ensure adequate ventilation in the lab so that the chances of chemical fumes building up are reduced
- Always mark the date of purchase and label the packaging of chemicals. This will keep track of the purity, expiration, or freshness of any chemical
- Additionally, always store chemicals of similar characteristics in specially designed cabinets, such as one for alcohols, one for acids, and one for bases
- If you have to store any flammable chemicals like sulfuric acid, you must acquire a specially designed cabinet
- Finally, it would help if you prioritized cleanliness when storing your chemicals; it will help avoid contamination
Find online Chemistry courses here on Superprof.
Chemistry Sets In The 21st Century
As more people realize that only science can find solutions to significant problems like world hunger and global warming, perhaps we may see another age of chemistry enthusiasts.
We discussed the importance of chemistry to the advancement of technology, and that can only happen as long as the youth find reasons to enter chemistry labs.
And learning how to use cool and complicated chemistry equipment gives them the motivation to do so – practical studies make them feel like adults and professionals.
If you have kids and are looking for practical Christmas or birthday present ideas, why not think out of the box? Give them something that can help them get into chemistry, like a set!
But a chemistry set would be useless for someone who isn't interested in the subject. Hence, with Superprof, you can get exceptional tutors near you and online so that your child can start their journey in science with style.
Find organic Chemistry tutor here on Superprof.
Summarize with AI:









